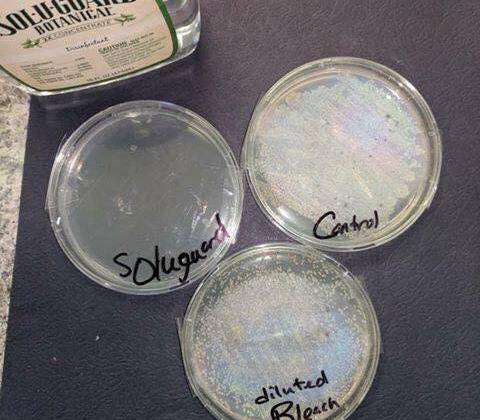

Yesterday, my cleaning lady used all these! She loved it! No chemical smell and safe for her.

We love our products!
Yesterday, my cleaning lady used all these! She loved it! No chemical smell and safe for her.

We love our products!

National Spring Cleaning week
Those friendly little scrub brushes pictured on Scrubbing Bubbles® Foaming Bleach Bathroom Cleaner look so cute, don’t they? The comercials are fun and cute too. What isn’t cute is the toxic chlorine bleach this product uses to clean. Bleach is toxic to people, animals, and our environment and it can irritate your nose, eyes, skin, and lungs. That’s why the label on every bottle of Scrubbing Bubbles recommends you use it in a “well-ventilated” area and wear protective gloves!
The hazards of common cleansers aren’t just hearsay. New research shows that toxic cleaning agents, like those found on grocery store shelves, are more damaging to human health than had been previously understood! A new, independent study based on 20 years of research reveals that cleaning with products like Scrubbing Bubbles as little as once per week is as damaging over time to your lungs as smoking a pack of cigarettes a day for 20 years! In fact, the researchers concluded that toxic, airborne ingredients like the vapors from chlorine bleach used in the cleaning products sold at grocery stores are among the most dangerous culprits.
Of course, none of this surprised me. I’ve been aware of the dangers of grocery store cleaning products for decades because of my asthma and allergies. That’s why I was thrilled to find a manufacturer who has been developing safer, more effective alternatives to accomplish all of my household chores without subjecting me or my family to the toxic chemical agents used in so many of today’s cleaning products.
My bathroom cleaner is the perfect example of a safer, more effective alternative. It delivers superior results without any of the toxic side effects. Soap scum and water spots dissolve harmlessly with the power of citric acid—the kind found in lemons. My health isn’t endangered and my family isn’t put at risk when rinse my tub, sinks, and showers. It smells great and cleans fast leaving shining surfaces.

I don’t know what you use, but in our house it isn’t open for discussion. I’m glad I got the toxic chemicals out of my home…it’s improved the health of my family and my home environment and that’s what matters to me. The toxic ingredients in Scrubbing Bubbles cleaners are harmful to women and every family member—they leave behind a toxic chemical footprint. All my cleaser leaves behind is a fresh fragrance, a sparkling clean bathroom, and incomparable peace of mind.
That’s our philosophy on cleaning.
For more than 30 years, my favorite shopping club’s innovative cleaning products have used natural and biodegradable ingredients that clean even more effectively without damaging the environment. None of these cleaners contain chlorine bleach, ammonia, formaldehyde, or other toxic chemicals. As a result, none of them requires a childproof cap.
As I’ve mentioned in previous posts they are also the market leader in concentrated formulas. By making their cleaning products as concentrated as possible, they use less plastic packaging, less fuel in shipping, and generate less waste. They believe that adding fillers to cleaning products is a waste of resources and customers’ money.
Larger bottles not only waste plastic, but water is heavy and costly to ship. Packaging and shipping water is an expensive and wasteful endeavor—and completely unnecessary. Almost every household in the developed world has water available at the sink at almost no cost to the customer. These unprecedented, super concentrated formulas are the result of state-of-the-art manufacturing and careful, scientific selection of ingredients.
For years, I’ve been using EcoSense cleaners and I wouldn’t be without them . Each one helps make my house sparkle and smell great.
Here’s a closer look at each one:
Tough & Tender® 12x Super-Concentrated All-Purpose Cleaner
Tub & Tile™ 12x Super-Concentrated Bathroom Cleaner
No Work® 12x Super-Concentrated Daily Shower Cleaner
Clear Power® 12x Super-Concentrated Glass Cleaner
Each of these great products offers all the cleaning power I love in a small, more condensed size not found anywhere else. For safer formulas, better value, and unmatched innovation, nothing’s better for my home and family than EcoSense.
The labels make it easy to understand how to use the products, what’s in them, and what makes them the best on the market. All the information I need to know is clearly visible, making it easier than ever to keep my home safe and clean. I just can’t help share this information,especially since it’s National Cleaning week.
Are you as passionate about your cleaning products?


After a new, independent study concluded that cleaning your home as little as once a week with national brand cleaners was as dangerous for your lungs as smoking a pack a day for twenty years, some parents are seriously wondering if cleaning the house is worth it at all—and who would blame them?
If adult lungs suffer when we breathe in the dangerous chemicals of national brand cleaning products, what about the developing lungs of children?
Yes, it’s just what you suspected: toxic chemicals are extremely dangerous for your children.
Here is what you need to know about hazardous chemicals and your child’s lungs:
• While toxins threaten everyone’s health, infants and children are especially sensitive to toxins and are very susceptible to air pollution
• Children are more vulnerable to chemicals (pound-by-pound because of their smaller body weight)
• Children’s bodies are less able to detoxify because their organs are not fully developed
If the hazardous chemicals in national brand cleaners are affecting adult respiratory health, imagine what they are doing to children who live in the same home, eat in the same kitchen, bathe in the same bathrooms, walk on the same floors, and breathe the same air! Their little lungs—so pure and clean—should be breathing air that is equally as pure and clean.
Giving up on cleaning all together (as tempting as that may sound some days) is not the answer. Living in filth comes with its own frightening threats to children’s health.
The good news is, it’s possible to provide your little ones with the home environment they deserve—freshly scrubbed, tidy and clean (even disinfected)—without harsh, toxic, organ-damaging chemicals.
EcoSense products are scientifically formulated to get your house sparkling clean without ammonia, chlorine bleach, quaternary disinfectants, or other dangerous chemicals. In fact, these cleaning products are so safe that no child safety caps are required.
These products are so good, they are all I’ve used for the past 15 years! During that time asthma and allergy attacks have been reduced to almost non-existent and this is with reduced medication. I’m healthier and saving money. You too can have a clean home that is also toxin-free! You only need to switch stores and get EcoSense the safer, more effective alternative.

We are partnered with a company committed to providing the products our customers need for the ultimate in healthy living. We pride ourselves on being part of the Wellness Company. From supplements to foods to home cleaning products, the products you bring into your home do make a difference.
We are pleased to see the scientific community draw unequivocal conclusions about topics we have been using for years. We are confident that as the facts about competitors’ products become more widely known, more consumers than ever will seek out the products that only our partner company can provide.
Full Study: Cleaning at home and at work in relation to lung function decline and airway obstruction
National Cleaning Week – Begins on March 24 and ends April 2


Did you know that every 13 seconds a family calls a poison control center?
Like most people, you want a clean home. Yet, every day over 300 children in the United States require emergency medical care due to accidental poisonings by household items.
You’re busy, and on a budget, so you need cleaning products that bust through grime without busting your bank account. You want a safe home, but caustic chemicals like chlorine bleach around the house can be hazardous. Many cleaning products are so harsh they can’t come in direct contact with your skin. they need to be stored high, out of reach of children, and they come with safety caps and warnings if accidentally ingested. Yet you are expected to slather them on your counter tops, sinks and floors.
Harsh chemicals aren’t just hard on your skin, they’re also hard on your home and our planet. They contaminate water supplies, leach into the soil and have to be stored as hazardous waste.
Cleaning your home shouldn’t involve putting your family at risk.
The first step is to educate yourself as a consumer, the next step is to eliminate toxins from your daily life. Like they say, an educated consumer always makes smarter choices.
That’s why I decided to avoid the caustic chemicals and abrasives that are contained in so many cleaners. I was tired of seeing reddened hands and rashes every time I cleaned the house—not to mention th sneezing, coughing, wheezing and asthma attacks. It seemed that not only was I reacting to dust, I was reacting to the cleaning products!
I found a great group of American-made products with formulas sourced from natural ingredients that won’t leave behind dangerous chemicals and poisons. All of my new products are free of chlorine bleach, ammonia, formaldehyde, phosphates, phthalates and other harsh chemicals. The best part? My side-effects from cleaning disappeared! Plus, I get the best of both worlds: effective cleaning, stain-lifting, deodorizing and disinfecting power without the danger of harsh chemicals. They also require NO child-safety caps!
Another bonus I discovered was my new brand also reduces my impact on the environment with biodegradable ingredients and ultra-concentrated formulas. The smaller bottles result in less plastic, water and fuel waste, while still giving me potent cleaning power that lasts longer than grocery store brands.
With all these benefits, you might expect that I’m paying premium-prices. Instead, these products save me money. Their concentrated formulas offer more cleaning power at less cost per use than many national brands. So, I get better quality at a better price. But that’s not all. Get this, my laundry products can also cut more than $10 a month from my power bill! Heating water for laundry uses 90% more energy than washing in cold water, and these products are specifically formulated to get my laundry clean in cold water.
That’s another reason why I switched to products that are better for me, my family, my home and budget and, of course, they work. So I can spend less time, stress and money on daily chores, and do more of the things that really matter. Now I never compromise clean for safe.
B

This picture caught your attention, didn’t it? Seems crazy right?
Who in their right mind would let their kids smoke cigarettes?
Then, why would you let them in a house cleaned with Clorox, Lysol, and Windex? A new, independent study based on 20 years of research reveals a sobering fact: cleaning your home with national brand cleaners significantly damages lung tissue.
How confident are you that these cleansers are safe? Nearly all of the national brand cleaning products you buy at the grocery store are made with a multitude of harmful chemicals. According to the study, some of the likely culprits are ammonia, chlorine bleach, and quaternary disinfectant compounds—among many others. Cleaning your home with products that contain dangerous chemicals as little as once per week was as damaging over time to respiratory health as smoking a pack of cigarettes a day for 20 years!
You don’t have to be a smoker to be at risk and the same goes for cleaning products—you don’t have to be the one cleaning. Just because you can’t see it damage it can cause doesn’t mean the products aren’t dangerous to you and your family.
Usually what exposes us the most are the things we never see coming. What’s stopping you from making better choices?
When the study, which was conducted by 28 top researchers from nine countries was peer-reviewed and published in the American Thoracic Society’s American Journal of Respiratory and Critical Care Medicine, it drew international media attention.
Here is a link to the study itself:
Cleaning at home and at work in relation to lung function decline and airway obstruction
After a thoughtful review of the study’s conclusions, I’m convinced you’ll see the urgency in removing national brand cleaners from your home and replacing them like I have, with the safer, more effective alternative products like EcoSense.
Recently a pharmacist customer wanted to put the chemical-free, botanical disinfectant I use and love daily because of its safety and great scent to the test. She didn’t believe my natural products could beat the products she uses for disinfecting areas. I said, “Let the science experiment begin!”
So she ordered some petri dishes and swabbed the absorbent pad that comes under raw chicken when packed by the butcher for grocery store. The first dish was left untouched as it was to be the Control.
The second dish was sprayed with the Department of Health standard sanitizing mixture of bleach and water. The standard disinfecting ratio is a one-quarter cup (minimum) to a three-quarter cup (maximum) cup of bleach to one gallon of cool water OR one tablespoon (minimum) to three tablespoons (maximum) of bleach to one quart of water. In this case, the later measurement amount (three tablespoons bleach to one quart of water was used.)
Finally, the third petri dish was sprayed with the natural, safe disinfectant I use, Sol-U-Gard.
The dishes were left in a warm spot next to our pharmacist customer’s computer overnight.
The photo shows the results of both disinfecting solutions in comparison to the control the following morning. Are you as surprised as she was?
Her question after seeing the results was “Why am I still using harmful, unsafe products like Clorox in my home?”
When there are safer options that work better and are EPA approved for use in hospitals and schools maybe you should ask yourself the same question. Isn’t your family and your health worth the safer options?
We thank our customer for sharing her test results and backing up what I know to be true, there are scientifically proven healthier and safer products available.